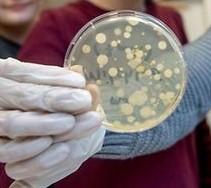

MINT AG im Schuldorf
Am neu errichteten MINT-Zentrum Schuldorf Bergstraße in Seeheim-Jugenheim können alle naturwissenschaftlich interessierten Schüler*innen ab der Jahrgangsstufe 5 im Bereich Mathematik, Informatik, Naturwissenschaften und Technik forschen. Begleitet werden sie dabei von Lehrkräften und Wissenschaftler*innen. Das Tolle dabei ist, dass die Forschungsthemen frei wählbar sind und keine Bewertung erfolgt. Manche der dort entwickelten Erfindungen werden auch bei „Jugend forscht“ eingereicht. Die MINT AG findet freitags ab 14 Uhr statt.
Diese Möglichkeit, eine MINT AG zu besuchen, ließen sich einige unserer Schüler*innen nicht entgehen. Und so trafen sich die zukünftigen Nachwuchswissenschaftler*innen am 24.5.2019 mit Frau Freydank und fuhren ins Schuldorf. Nach einer Einführung durch den Laborleiter Herrn Haxel stürzten sich viele ins Thema „Microcontrolling“ und hatten nach nur 1,5 Stunden eine Miniampel programmiert.

Im Chemielabor untersuchten zwei Schüler den Einfluss verschiedener Substanzen auf das Wachstum von Keimkulturen; die Temperatur wurde variiert und verschiedene Chemikalien ausprobiert….und das alles auf einem Klecks Spucke.
Zwischenzeitlich gingen unsere Melis zu den Schülern, die schon länger dabei sind und fragten diesen zu ihren Forschungsthemen Löcher in den Bauch, die diese mit Begeisterung beantworteten. Zusammenfassung: tolle Atmosphäre, super Ausstattung, nette Leute und viele spannende Fragen!
Anke Freydank






